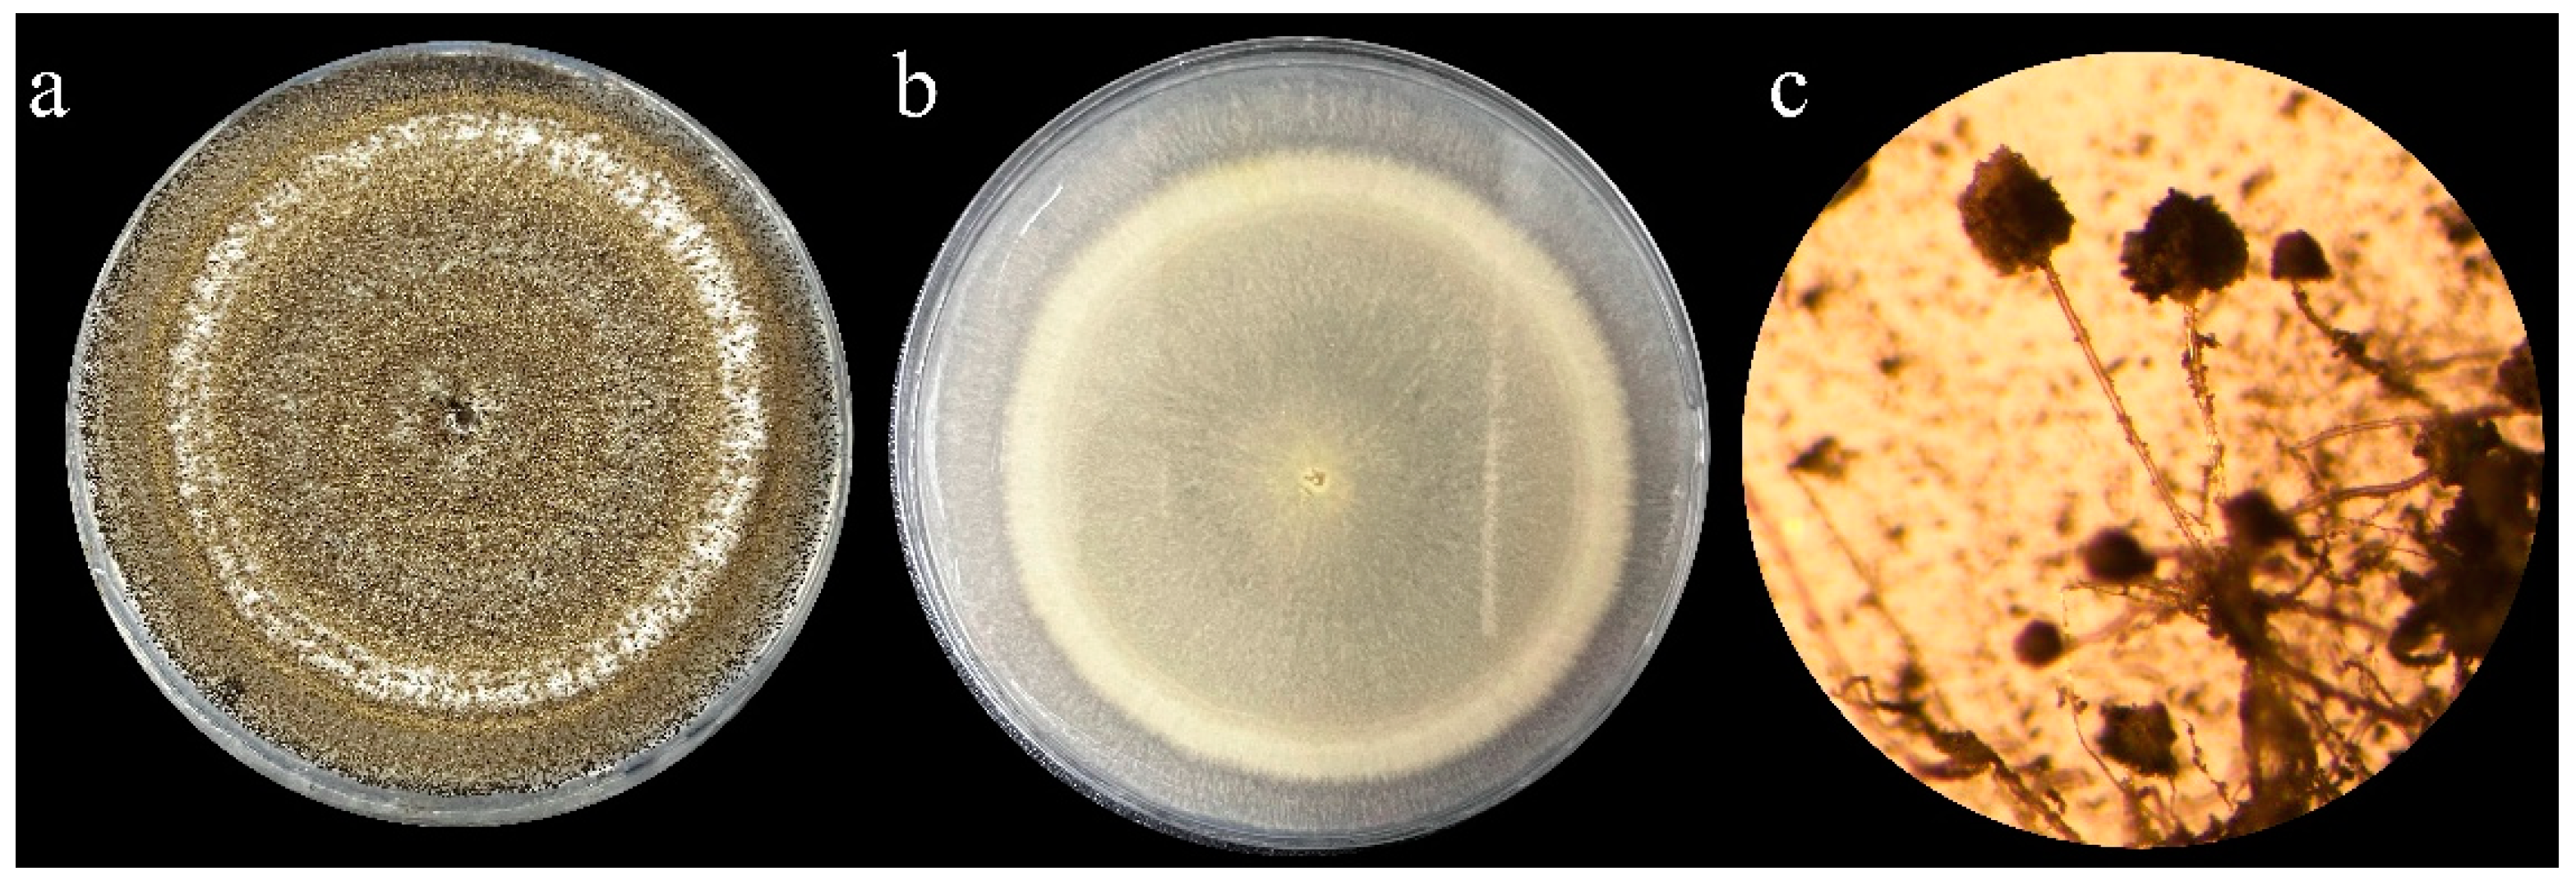
Agriculture 13 00122 g005 Agriculture 13 00122 g005
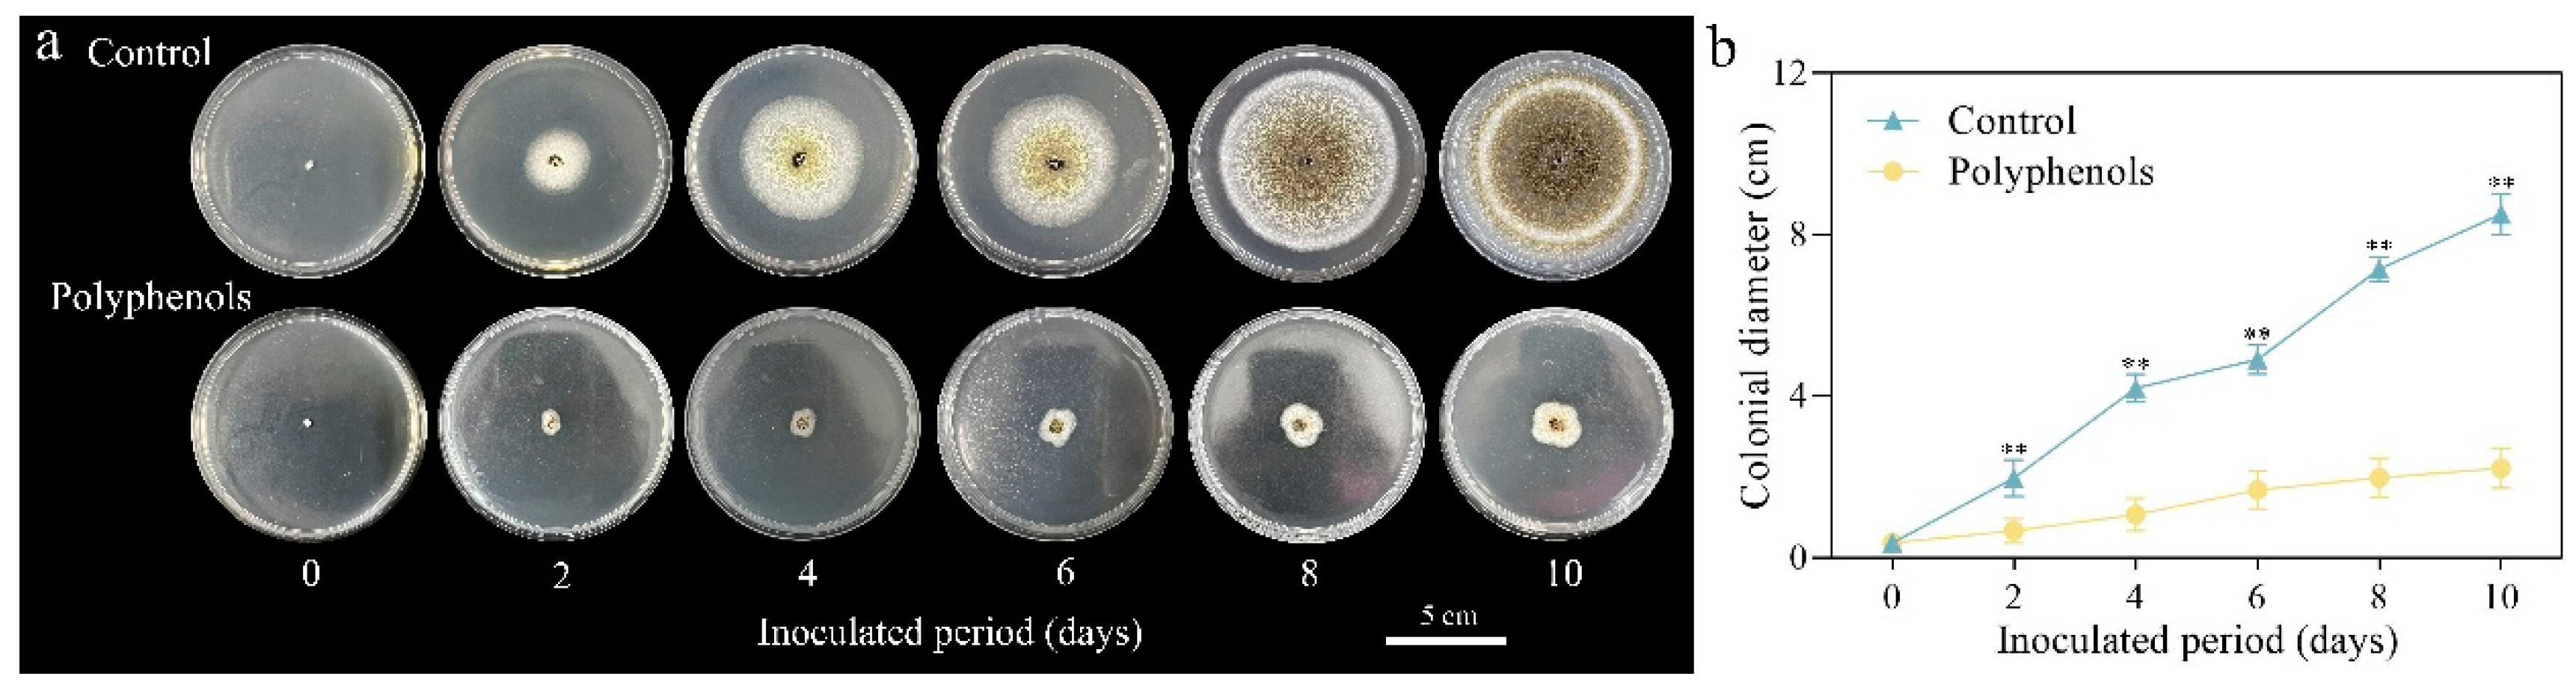
Agriculture 13 00122 g007 Agriculture 13 00122 g007

Herbaceous Peony Polyphenols Extend the Vase Life of Cut Flowers
Abstract
1. Introduction
2. Materials and Methods
2.1. Plant Materials
2.2. Preparation of Herbaceous Peony Polyphenol Extract
2.3. Measurement of Morphological Indexes
2.4. Measurement of Physiological Indexes and Protective Enzyme Activity
2.5. Microbe Identification
2.6. Antibacterial Efficacy of Herbaceous Peony Polyphenols Observation
2.7. Gene Isolation and Expression Analysis
2.8. Sequence and Statistical Analysis
3. Results
3.1. Effect of Polyphenols on Morphological Indices of Cut Herbaceous Peony Flowers
3.2. Effect of Polyphenols on Physiological Indices of Cut Herbaceous Peony Flowers
3.3. Effect of Polyphenols on Protective Enzyme Activities of Cut Herbaceous Peony Flowers
3.4. Microstructures of Stem Ends
3.5. Microbe Identification
3.6. Antibacterial Efficacy of Herbaceous Peony Polyphenols
3.7. Expression Analysis of AQPs
4. Discussion
5. Conclusions
Author Contributions
Funding
Institutional Review Board Statement
Data Availability Statement
Conflicts of Interest
References
- Zhou, S.; Xu, C.; Liu, J.; Yu, Y.; Wu, P.; Cheng, T.; Hong, D.Y. Out of the pan-Himalaya: Evolutionary history of the Paeoniaceae revealed by phylogenomics. J. Syst. Evol. 2021, 59, 1170–1182. [Google Scholar] [CrossRef]
- Chen, G.W. Study on the Thchniques of Postharvest Preservation in Cut Flower Paeonia Lactiflora Pall; Jilin Agricultural University: Changchun, China, 2021. [Google Scholar]
- Li, Y.; Li, L.N.; Wang, S.; Liu, Y.H.; Zou, J.X.; Ding, W.J.; Du, H.M.; Shen, W.B. Magnesium hydride acts as a convenient hydrogen supply to prolong the vase life of cut roses by modulating nitric oxide synthesis. Postharvest Biol. Technol. 2021, 177, 111526. [Google Scholar] [CrossRef]
- Kesta, S.; Imsabai, W.; Van Doorn, W.G. Effect of precooling and ethylene absorbent on the quality of Dendrobium ‘Pompadour’ flowers. Acta Hortic. 2005, 669, 367–371. [Google Scholar]
- Al-Humaid, A. Effect of glucose and, biocides on vase-life and quality of cut gladiolus spikes. Acta Hortic. 2005, 682, 519–525. [Google Scholar] [CrossRef]
- Wen, Y.Q.; Liu, Y.L.; Wang, R.H.; Xu, Y.Q. 6-BA and PP333 effects in shelf-life improvement of Tulipa gesneriana cut flowers. Xibei Zhiwu Xuebao 2005, 25, 2535–2538. [Google Scholar]
- Ichimura, K.; Goto, R. Extension of vase life of cut Narcissus tazetta var. chinensis flowers by combined treatment with STS and gibberellin A(3). J. Jpn. Soc. Hortic. Sci. 2002, 71, 226–230. [Google Scholar] [CrossRef]
- Onozaki, T.; Yamasa, M.; Yagi, M.; Tanase, K.; Shibata, M. Effects of Crossing and Selection for Seven Generations Based on Flower Vase Life in Carnations (Dianthus caryophyllus L.), and the Relationship between Ethylene Production and Flower Vase Life in the Breeding Lines. Hortic. J. 2018, 87, 106–114. [Google Scholar] [CrossRef]
- Park, J.; Kim, W.S. Preharvest Spraying of CaCl2 Alleviates the Scape Bending of Gerbera ‘Harmony’ Flowers by Strengthening the Pectin Crosslinks through Ca2+ Bonds. Horticulturae 2022, 8, 523. [Google Scholar] [CrossRef]
- García-Ávila, C.; Castillo-González, A.; Avitia-García, E.; Colinas-León, M.; Trejo-Téllez, L.; Vargas-Madriz, H. Magnesium and its relationship with quality of Lilium cv. Casablanca. Rev. Mex. Cienc. Agrícolas 2015, 6, 265–276. [Google Scholar]
- Kuroshima, M.; Ichimura, K.; Ubukata, M. Extension of Vase Life and Ag Content in Cut Flowers of Delphinium Treated with STS. Hortic. Res. (Japan) 2009, 8, 353–357. [Google Scholar] [CrossRef]
- Chuang, Y.C.; Chang, Y.C.A. The Role of Soluble Sugars in Vase Solutions during the Vase Life of Eustoma grandiflorum. Hortscience 2013, 24, 222–226. [Google Scholar] [CrossRef]
- Rattanawisalanon, C.; Ketsa, S.; Van Doorn, W.G. Effect of aminooxyacetic acid and sugars on the vase life of Dendrobium flowers. Postharvest Biol. Technol. 2003, 29, 93–100. [Google Scholar] [CrossRef]
- Han, L.; Sun, X.; Xu, J.G.; Li, Q.; Gao, C.R.; Lu, J.; Du, G.C. The influence of polyamine and polyamine inhibitors in herbaceous peony postharvest physiology. Int. J. Plant Physiol. 2018, 23, 499–506. [Google Scholar] [CrossRef]
- Mansouri, H. Salicylic acid and sodium nitroprusside improve postharvest life of chrysanthemums. Sci. Hortic. 2012, 145, 29–33. [Google Scholar] [CrossRef]
- Kazemzadeh-Beneh, H.; Samsampour, D.; Zarbakhsh, S. Biochemical, physiological changes and antioxidant responses of cut gladiolus flower ‘White Prosperity’ induced by nitric oxide. Adv. Hortic. Sci. 2018, 32, 421–431. [Google Scholar]
- Mashhadian, N.V.; Tehranifar, A.; Bayat, H.; Selahvarzi, Y. Salicylic and Citric Acid Treatments Improve the Vase Life of Cut Chrysanthemum Flowers. J. Agric. Sci. Technol. 2012, 14, 879–887. [Google Scholar]
- Tang, W.H. Physiological Effects of Nano-Silver on the Vase Life in Cut Flower Paeonia Lactiflora Pall; Yangzhou University: Yangzhou, China, 2016. [Google Scholar]
- Hughes, D.A. Plant polyphenols: Modifiers of immune function and risk of cardiovascular disease. Nutrition 2005, 21, 422–423. [Google Scholar] [CrossRef]
- Zhou, X.R.; Zhang, Y.; Jiang, B. Extraction and Electrochemical Analysis of Polyphenols in Plant Samples. Electrochem 2019, 14, 7410–7422. [Google Scholar] [CrossRef]
- Bae, J.Y.; Seo, Y.H.; Oh, S.W. Antibacterial activities of polyphenols against foodborne pathogens and their application as antibacterial agents. Food Sci. Biotechnol. 2022, 31, 985–997. [Google Scholar] [CrossRef]
- Xia, E.Q.; Deng, G.F.; Guo, Y.J.; Li, H.B. Biological Activities of Polyphenols from Grapes. Int. J. Mol. Sci. 2012, 23, 174–181. [Google Scholar]
- Manach, C.; Williamson, G.; Morand, C.; Scalbert, A.; Remesy, C. Bioavailability and bioefficacy of polyphenols in humans. I. Review of 97 bioavailability studies. Am. J. Clin. Nutr. 2005, 81, 230S–242S. [Google Scholar] [CrossRef] [PubMed]
- Kim, H.S.; Quon, M.J.; Kim, J.A. New insights into the mechanisms of polyphenols beyond antioxidant properties; lessons from the green tea polyphenol, epigallocatechin 3-gallate. Redox Biol. 2003, 43, 89–143. [Google Scholar] [CrossRef] [PubMed]
- Ma, T.T.; Tian, C.R.; Luo, J.Y.; Zhou, R.; Sun, X.Y.; Ma, J.J. Influence of technical processing units on polyphenols and antioxidant capacity of carrot (Daucus carrot L.) juice. Food Chem. 2013, 141, 1637–1644. [Google Scholar] [CrossRef] [PubMed]
- Xu, C.M.; Yagiz, Y.; Hsu, W.Y.; Simonne, A.; Lu, J.; Marshall, M.R. Antioxidant, Antibacterial, and Antibiofilm Properties of Polyphenols from Muscadine Grape (Vitis rotundifolia Michx.) Pomace against Selected Foodborne Pathogens. J. Agric. Food Chem. 2014, 62, 6640–6649. [Google Scholar] [CrossRef]
- Zhang, Z.D.; Liu, M.C.; Xu, L.Q.; Zhao, C.Z.; Li, H. Research of Tea Polyphenols on Post-harvest Biochemical Metabolism and Preservation in Cut Rose Flowers. Storage Process 2007, 6, 13–18. [Google Scholar]
- Chen, G.L.; Chen, F.; Xie, Y.C.; Luo, C.X.; Shi, R.F.; Li, J.; Chen, S.G. Study on the Extraction and Antioxidant Activity of Phenolic Contents from the Flower of Paeonia lactiflora Pall. Food Res. Dev. 2017, 38, 39–44. [Google Scholar]
- Skutnik, E.; Rabiza-Świder, J.; Jędrzejuk, A.; Łukaszewska, A. The effect of the long-term cold storage and preservatives on senescence of cut herbaceous peony flowers. Agronomy 2020, 10, 1631. [Google Scholar] [CrossRef]
- Ezhilmathi, K.; Singh, V.P.; Arora, A.; Sairam, R.K. Effect of 5-sulfosalicylic acid on antioxidant activity in relation to vase life of Gladiolus cut flowers. Plant Growth Regul. 2007, 51, 99–108. [Google Scholar] [CrossRef]
- Wang, S.L.; Lv, Y.M. Research progress on postharvest physiology and storage and transportation technology of Andrographis cut flowers. North Hortic. 2009, 4, 128–131. [Google Scholar]
- Fan, H.M.; Li, T.; Sun, X.; Sun, X.Z.; Zheng, C.S. Effects of humic acid derived from sediments on the postharvest vase life extension in cut chrysanthemum flowers. Postharvest Biol. Technol. 2015, 101, 82–87. [Google Scholar] [CrossRef]
- Zheng, M.; Guo, Y. Cerium improves the vase life of Dianthus caryophyllus cut flower by regulating the ascorbate and glutathione metabolism. Sci. Hortic. 2018, 240, 492–495. [Google Scholar] [CrossRef]
- Hodges, D.M.; Lester, G.E.; Munro, K.D.; Toivonen, P.M.A. Oxidative stress: Importance for postharvest quality. HortScience 2004, 39, 924–929. [Google Scholar] [CrossRef]
- Peng, Y.H.; Song, L.L.; Li, L. Recent advances on physiology of senescence and technologies of preservation and transportation of freshly cut flowers. J. South China Norm. Univ. (Nat. Sci. Ed.) 2002, 2, 120–126. [Google Scholar]
- Khalofah, A.; Migdadi, H.; El-harty, E. Antioxidant Enzymatic Activities and Growth Response of Quinoa (Chenopodium quinoa Willd.) to Exogenous Selenium Application. Plants 2021, 10, 719. [Google Scholar] [CrossRef]
- Song, L.L.; Liu, H.; You, Y.L.; Sun, J.; Yi, C.; Li, Y.B.; Jiang, Y.M.; Wu, J.S. Quality deterioration of cut carnation flowers involves in antioxidant systems and energy status. Sci. Hortic. 2014, 170, 45–52. [Google Scholar] [CrossRef]
- Wen, J.F.; Chi, B.W.; Peng, C.X.; Deng, M.H. 2,4-epibrassinolide relieves the damage of drought stress on fresh-cut lilies by increasing antioxioant enzyme activities. Pak. J. Bot. 2022, 54, 2043–2049. [Google Scholar]
- Zulfiqar, F.; Nafees, M.; Darras, A.; Shaukat, N.; Chen, J.J.; Ferrante, A.; Zaid, A.; Latif, N.; Raza, A.L.; Siddique, K.H.M. Pre-harvest potassium foliar application improves yield, vase life and overall postharvest quality of cut gladiolus inflorescences. Postharvest Biol. Technol. 2022, 192, 112027. [Google Scholar] [CrossRef]
- Rabiza-Świder, J.; Skutnik, E.; Jędrzejuk, A.; Lukaszewska, A. Postharvest treatments improve quality of cut peony flowers. Agronomy 2020, 10, 1583. [Google Scholar] [CrossRef]
- Yilmaz, D.; Gokduman, M.E. Effect of Moisture Contents on Physical-Mechanical Properties of Lavandin (Lavandula X Intermedia Emeric Ex Loisel.). J. Essent. Oil-Bear. Plants 2015, 17, 1224–1232. [Google Scholar] [CrossRef]
- Mujaffar, S. Water-balance in cut anthurium flowers in storage and its effect on quality. Acta Hortic. 1994, 368, 723–732. [Google Scholar]
- Williamson, V.G.; Joyce, D.C. Boronia heterophylla vase life is influenced more by ethylene than by bacterial numbers or vase solution pH. Postharvest Biol. Technol. 2013, 84, 28–35. [Google Scholar] [CrossRef]
- Li, H.M.; Huang, X.M.; Li, J.B.; Liu, J.P.; Joyce, D.; He, S.G. Efficacy of nano-silver in alleviating bacteria-related blockage in cut rose cv. Movie star stems. Postharvest Biol. Technol. 2012, 74, 36–41. [Google Scholar] [CrossRef]
- Chen, J.; Nadar, V.S.; Rosen, B.P. Aquaglyceroporin AqpS from Sinorhizobium meliloti conducts both trivalent and pentavalent methylarsenicals. Chemosphere 2021, 270, 129379. [Google Scholar] [CrossRef] [PubMed]
- Sorani, M.D.; Manley, G.T.; Giacomini, K.M. Genetic variation in human aquaporins and effects on phenotypes of water homeostasis. Hum. Mutat. 2008, 29, 1108–1117. [Google Scholar] [CrossRef]
- Chaumont, F.; Barrieu, F.; Wojcik, E.; Chrispeels, M.J.; Jung, R. Aquaporins constitute a large and highly divergent protein family in maize. Plant Physiol. 2001, 125, 1206–1215. [Google Scholar] [CrossRef]
- Kong, W.L.; Hu, R.; Bao, M.Z.; Fu, X.P. Cloning and Expression Analysis of the Aquaporin Genes in Carnation. Acta Hortic. Sin. 2017, 44, 515–527. [Google Scholar]
- Ye, X.Y.; Gao, Y.S.; Chen, C.B.; Xie, F.F.; Hua, Q.Z.; Zhang, Z.K.; Zhang, R.; Zhao, J.T.; Hu, G.B.; Qin, Y.H. Genome-Wide Identification of Aquaporin Gene Family in Pitaya Reveals an HuNIP6;1 Involved in Flowering Process. Int. J. Mol. Sci. 2021, 22, 7689. [Google Scholar] [CrossRef]
- Ma, N.; Xue, J.Q.; Li, Y.H.; Liu, X.J.; Dai, F.W.; Jia, W.S.; Luo, Y.B.; Gao, J.P. Rh-PIP2;1, a Rose Aquaporin Gene, Is Involved in Ethylene-Regulated Petal Expansion. Plant Physiol. 2008, 148, 894–907. [Google Scholar] [CrossRef]
- Zhao, D.Q.; Cheng, M.L.; Tang, W.H.; Liu, D.; Zhou, S.Y.; Meng, J.S.; Tao, J. Nano-silver modifies the vase life of cut herbaceous peony (Paeonia lactiflora Pall.) flowers. Protoplasma 2018, 255, 1001–1013. [Google Scholar] [CrossRef]
- Ricardo, A.; Rose, P.; Juan, M.R. Regulation of root water uptake under abioic sress conditions. J. Exp. Bot. 2012, 63, 43–57. [Google Scholar]

| Gene | Forward Prime | Reverse Prime |
|---|---|---|
| Actin | ACTGCTGAACGGGAAATT | ATGGCTGGAACAGGACTT |
| PIP1-2 | TTGGGGCTGAGATTATTG | GGAATGGTAGCCAAATGA |
| PIP2-1 | CCTGTCTTGGCTCCACTT | CCCATGCTTTCTCATTATT |
| PIP2-2 | AGACTTCTGGAATGCCTTGA | TATAAATCCGGCGGTGAC |
| NIP | ATATTCCGTTGGTCACATCT | CTAGGGTTGAACCAAGAAGT |
Disclaimer/Publisher’s Note: The statements, opinions and data contained in all publications are solely those of the individual author(s) and contributor(s) and not of MDPI and/or the editor(s). MDPI and/or the editor(s) disclaim responsibility for any injury to people or property resulting from any ideas, methods, instructions or products referred to in the content. |
© 2023 by the authors. Licensee MDPI, Basel, Switzerland. This article is an open access article distributed under the terms and conditions of the Creative Commons Attribution (CC BY) license (https://creativecommons.org/licenses/by/4.0/).
Share and Cite
Li, P.; Zhang, W.; Tao, J.; Zhao, D. Herbaceous Peony Polyphenols Extend the Vase Life of Cut Flowers. Agriculture 2023, 13, 122. https://doi.org/10.3390/agriculture13010122
Li P, Zhang W, Tao J, Zhao D. Herbaceous Peony Polyphenols Extend the Vase Life of Cut Flowers. Agriculture. 2023; 13(1):122. https://doi.org/10.3390/agriculture13010122
Chicago/Turabian StyleLi, Pinyue, Weiming Zhang, Jun Tao, and Daqiu Zhao. 2023. "Herbaceous Peony Polyphenols Extend the Vase Life of Cut Flowers" Agriculture 13, no. 1: 122. https://doi.org/10.3390/agriculture13010122
APA StyleLi, P., Zhang, W., Tao, J., & Zhao, D. (2023). Herbaceous Peony Polyphenols Extend the Vase Life of Cut Flowers. Agriculture, 13(1), 122. https://doi.org/10.3390/agriculture13010122






